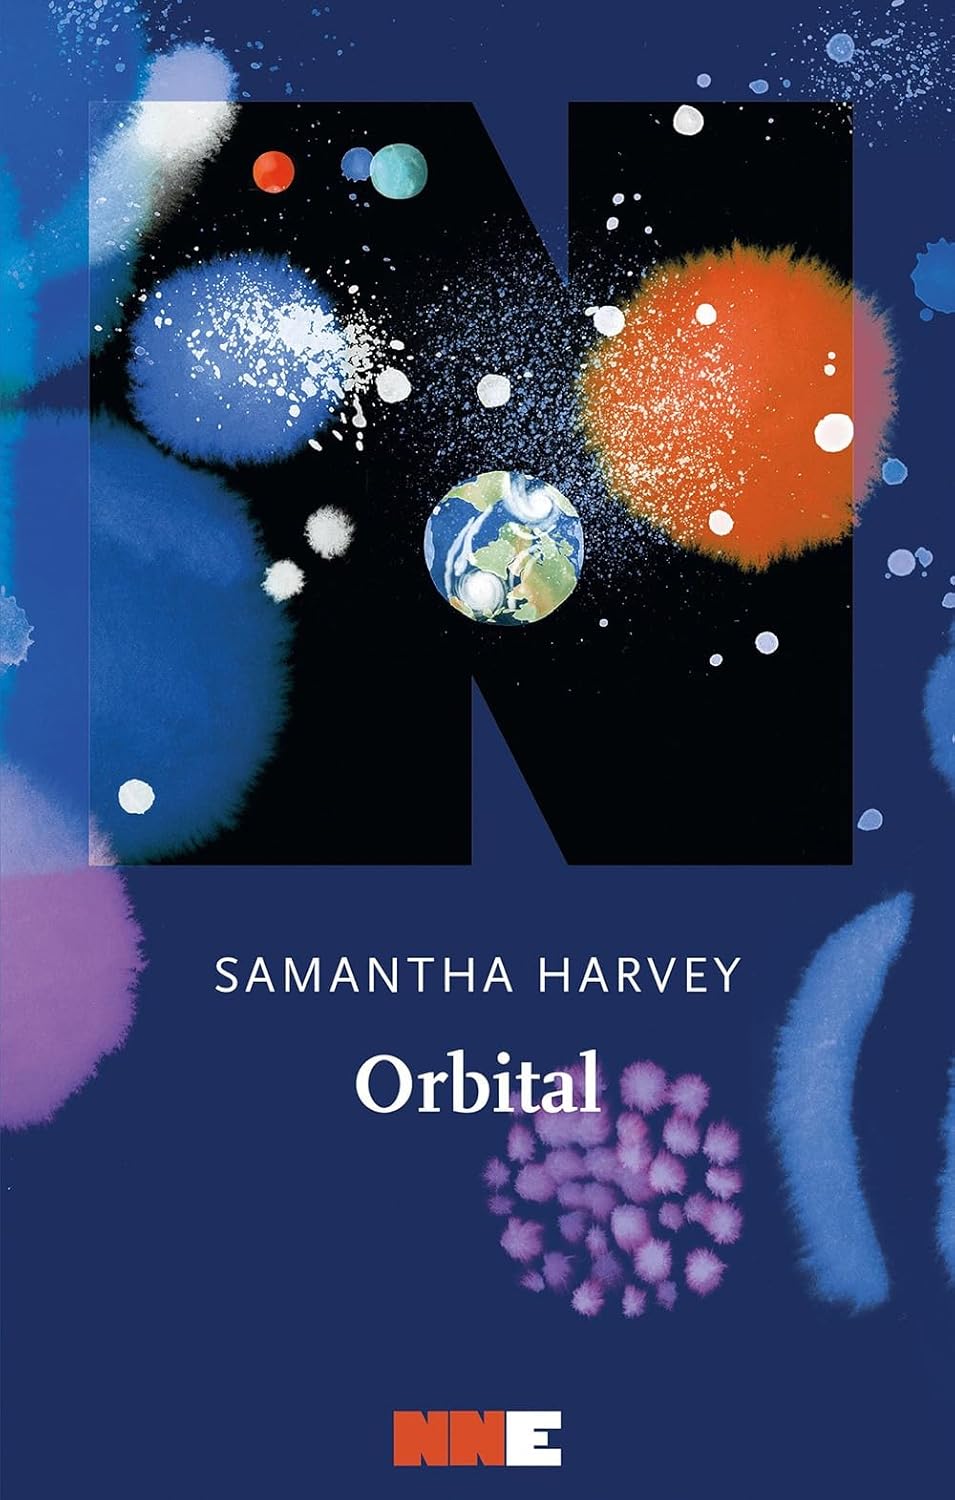

Orbital
Orbital
Nel cuore nero del cosmo, sei astronauti viaggiano in orbita attorno alla Terra, a bordo di una stazione spaziale. Vengono dall'America, dalla Russia, dall'Italia, dalla Gran Bretagna e dal Giappone, e sono partiti per studiare il silenzioso pianeta blu, su cui scorre intensa la vita da cui sono esclusi: un matrimonio in crisi, un funerale, un fratello ammalato, un tifone che minaccia devastazione. Li vediamo nei brevi momenti di intimità in cui preparano pasti disidratati, fanno ginnastica per non perdere massa, dormono a mezz'aria in assenza di gravità, stringono legami tra loro per sottrarsi alla solitudine. Ognuno è preso dai propri pensieri e dal proprio passato terrestre, ma più scorre il tempo più cominciano a sentirsi parti di un unico corpo – Pietro la mente, Anton il cuore, Roman le mani, Chie la coscienza, Shaun l'anima e Nell il respiro. Profondo e commovente, Orbital è un canto d'amore alla bellezza dell'universo e del nostro pianeta, che osservato da lontano diventa prezioso e precario, un gioiello sospeso nell'infinito, un paradiso da proteggere. Con voce incantata, Samantha Harvey ci ricorda che di fronte all'immensità del tempo e dello spazio siamo solo piccole foglie al vento, e che la nostra esistenza è scritta dal futuro che riusciamo a sognare.
